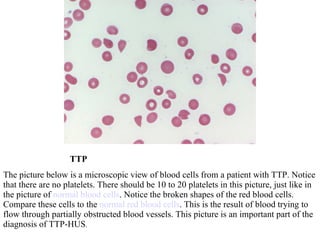
TTP The picture below is a microscopic view of blood cells from a patient with TTP. Notice that there are no platelets. There should be 10 to 20 platelets in this picture, just like in the picture of  normal blood cells . Notice the broken shapes of the red blood cells. Compare these cells to the  normal red blood cells . This is the result of blood trying to flow through partially obstructed blood vessels. This picture is an important part of the diagnosis of TTP-HUS .
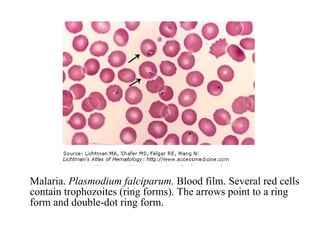
Malaria, falciparum Malaria.  Plasmodium falciparum.  Blood film. Several red cells contain trophozoites (ring forms). The arrows point to a ring form and double-dot ring form.
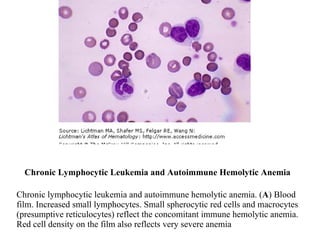
Chronic Lymphocytic Leukemia and Autoimmune Hemolytic Anemia Chronic lymphocytic leukemia and autoimmune hemolytic anemia. ( A ) Blood film. Increased small lymphocytes. Small spherocytic red cells and macrocytes (presumptive reticulocytes) reflect the concomitant immune hemolytic anemia. Red cell density on the film also reflects very severe anemia
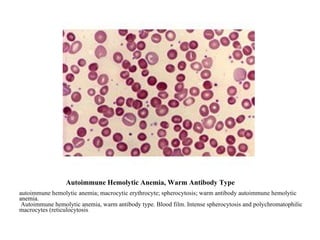
Autoimmune Hemolytic Anemia, Warm Antibody Type autoimmune hemolytic anemia; macrocytic erythrocyte; spherocytosis; warm antibody autoimmune hemolytic anemia.    Autoimmune hemolytic anemia, warm antibody type. Blood film. Intense spherocytosis and polychromatophilic macrocytes (reticulocytosis ).

The document contains medical images and descriptions of various conditions:
1) Images show lesions and rashes characteristic of conditions like pyoderma gangrenosum, dermatitis herpetiformis, and livedo reticularis.
2) Radiographic images depict abnormalities related to osteonecrosis, DISH syndrome, and Gardner's syndrome.
3) Microscopic slides show cellular features of diseases such as malaria, CLL, and Goodpasture's syndrome.